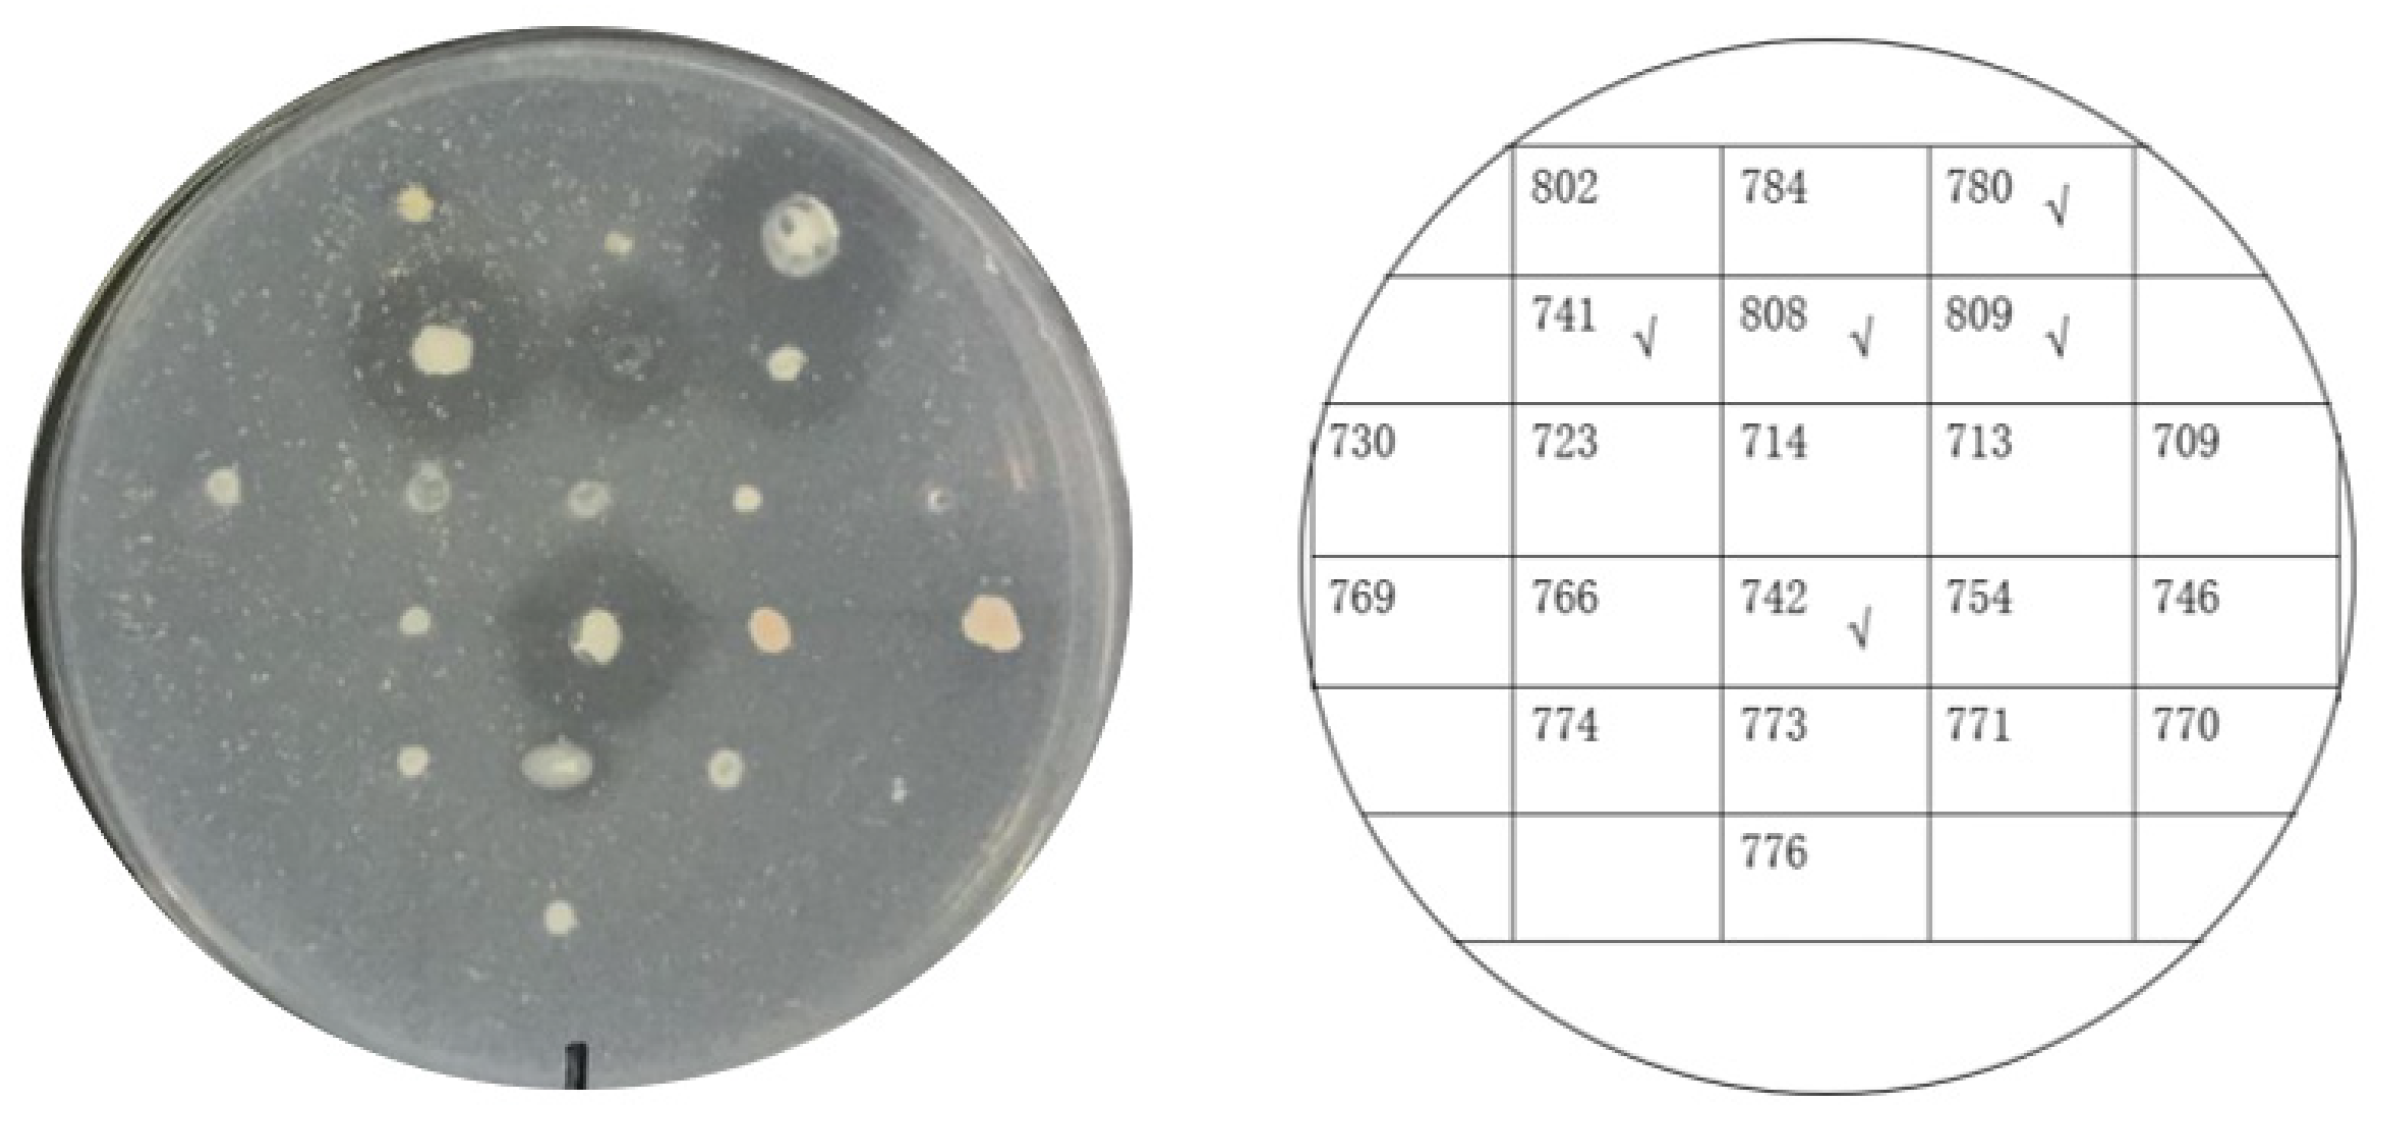
Biomolecules 12 00318 g004

Degradation of CP4-EPSPS with a Psychrophilic Bacterium Stenotrophomonas maltophilia 780
Abstract
:1. Introduction
2. Materials and Methods
2.1. Bacteria, Plasmids, Media, and Reagents
2.2. Expression and Purification of the Recombinant CP4-EPSPS
2.3. SDS–PAGE Assay of the Proteins of Interest
2.4. Analyzing the Stability of Recombinant CP4-EPSPS
2.5. Analyzing the Extracellular Protease Activity of the Psychrophilic Bacteria from the South Polar Region
2.6. Digestion of CP4-EPSPS with Extracellular Proteases Generated by Psychrophilic Bacteria
2.7. Isolating a Pure Culture of S. maltophilia 780 and Microscopy Assay
2.8. 16S rDNA Sequence Assay and Genomic Sequencing
2.9. Inducing Extracellular Proteases of S. maltophilia 780 with Various Nitrogen Sources
2.10. Quantitatively Analyzing the Extracellular Proteases of S. maltophilia 780
2.11. Preparation of Roundup Ready Soybean (RRS) Extract
2.12. ELISA
3. Results
3.1. Recombinant Expression of CP4-EPSPS
3.2. Stability of the Recombinant CP4-EPSPS
3.3. Screening Psychrophilic Bacteria Strains Capable of Degrading the Recombinant CP4-EPSPS
3.4. Identification of Psychrophilic Bacteria CCTCC2016780
3.5. Characteristics of the Extracellular Proteases of S. maltophilia 780
3.6. Degradation of CP4-EPSPS in RRS with S. maltophilia 780a
3.7. Genomic Sequencing of S. maltophilia 780 and the Genes Encoding Proteases
4. Discussions
Supplementary Materials
Author Contributions
Funding
Institutional Review Board Statement
Informed Consent Statement
Data Availability Statement
Conflicts of Interest
References
- ISAAA. Global Status of Commercialized Biotech/GM Crops; ISAAA: Ithaca, NY, USA, 2016; Volume 52. [Google Scholar]
- Steinrücken, H.C.; Amrhein, N. The herbicide glyphosate is a potent inhibitor of 5-enolpyruvyl-shikimic acid-3-phosphate synthase. Biochem. Biophys. Res. Commun. 1980, 94, 1207–1212. [Google Scholar] [CrossRef]
- Hoagland, R.E.; Jordan, R.H.; Teaster, N.D. Bioassay and Characterization of Several Palmer Amaranth (Amaranthus palmeri) Biotypes with Varying Tolerances to Glyphosate. Am. J. Plant Sci. 2013, 4, 1029–1037. [Google Scholar] [CrossRef] [Green Version]
- Barry, G.; Kishore, G.; Padgette, S. Inhibitors of amino acid biosynthesis: Strategies for imparting glyphosate tolerance to crop plants. Curr. Top. Plant Physiol. 1992, 7, 139–145. [Google Scholar]
- Padgette, S.R.; Kolacz, K.H.; Delannay, X. Development, identification, and characterization of a glyphosate-tolerant soybean line. Crop Sci. 1995, 35, 1451–1461. [Google Scholar] [CrossRef]
- Howe, A.R.; Gasser, C.S.; Brown, S.M. Glyphosate as a selective agent for the production of fertile transgenic. Mol. Breed. 2002, 10, 153–164. [Google Scholar] [CrossRef]
- Chhapekar, S.; Raghavendrarao, S.; Pavan, G.; Ramakrishna, C.; Singh, V.K.; Phanindra, M.L.; Dhandapani, G.; Sreevathsa, R.; Ananda Kumar, P. Transgenic rice expressing a codon-modified synthetic CP4-EPSPS confers tolerance to broad-spectrum herbicide, glyphosate. Plant Cell Rep. 2015, 34, 721–731. [Google Scholar] [CrossRef]
- Cerny, R.E.; Bookout, J.T.; CaJacob, C.A.; Groat, J.R.; Hart, J.L.; Heck, G.R.; Huber, S.A.; Listello, J.; Martens, A.B.; Oppenhuizen, M.E.; et al. Development and Characterization of a Cotton (Gossypium hirsutum L.) Event with Enhanced Reproductive Resistance to Glyphosate. Crop Sci. 2010, 50, 1375–1384. [Google Scholar] [CrossRef]
- Marvier, M.; Van Acker, R.C. Can crop transgenes be kept on a leash? Front. Ecol. Environ. 2005, 3, 99–106. [Google Scholar] [CrossRef]
- Chinnadurai, P.; Stojšin, D.; Liu, K.; Frierdich, G.E.; Glenn, K.C.; Geng, T.; Schapaugh, A.; Huang, K.; Deffenbaugh, A.E.; Liu, Z.L.; et al. Variability of CP4 EPSPS expression in genetically engineered soybean (Glycine max L. Merrill). Transgenic Res. 2018, 27, 511–524. [Google Scholar] [CrossRef] [Green Version]
- Shi, Z.; Zou, S.; Lu, C.; Wu, B.; Huang, K.; Zhao, C.; He, X. Evaluation of the effects of feeding glyphosate-tolerant soybeans (CP4 EPSPS) on the testis of male Sprague-Dawley rats. GM Crop. Food 2019, 10, 181–190. [Google Scholar] [CrossRef] [PubMed]
- Ali, Q.; Salisu, I.B.; Shahid, A.A.; Liaqat, A.; Rao, A.Q. A 90-day subchronic toxicity study of transgenic cotton expressing Cry1Ac, Cry2A and CP4-EPSPS proteins in Sprague-Dawley rats. Food Chem. Toxicol. 2020, 146, 111783. [Google Scholar] [CrossRef] [PubMed]
- Salisu, I.B.; Shahid, A.A.; Yaqoob, A.; Rao, A.Q.; Husnain, T. Effect of dietary supplementation of recombinant Cry and Cp4 epsps proteins on haematological indices of growing rabbits. J. Anim. Physiol. Anim. Nutr. 2019, 103, 305–316. [Google Scholar] [CrossRef] [PubMed] [Green Version]
- Wu, H.; Wang, X.; Zhou, X.; Zhang, Y.; Huang, M.; He, J.; Shen, W. Targeting the middle region of CP4-EPSPS protein for its traceability in highly processed soy-related products. Food Sci. Technol. 2017, 54, 3142–3151. [Google Scholar] [CrossRef] [PubMed]
- Alam, S.I.; Dube, S.; Reddy, G.S.N.; Bhattacharya, B.K.; Shivaji, S.; Singh, L. Purification and characterisation of extracellular protease produced by Clostridium sp. from Schirmacher oasis, Antarctica. Enzym. Microb. Technol. 2005, 36, 824–831. [Google Scholar] [CrossRef]
- Ragupathi, N.K.D.; Veeraraghava, B. Data on whole genome shotgun sequencing report of clinical S. maltophilia strains from India. Data Brief 2018, 21, 263–268. [Google Scholar] [CrossRef]
- Morita, R.Y. Psychrophilic bacteria. Bacteriol. Rev. 1975, 39, 144–167. [Google Scholar] [CrossRef]
- Collins, T.; Margesin, R. Psychrophilic lifestyles: Mechanisms of adaption and biotechnological tools. Appl. Microbiol. Biotechnol. 2019, 103, 2857–2871. [Google Scholar] [CrossRef]
- Aislabie, J.; Saul, D.J.; Foght, J.M. Bioremediation of hydrocarbon-contaminated polar soils. J. Extrem. 2006, 10, 171–179. [Google Scholar] [CrossRef]
- Lin, X.; Yang, B.; Shen, J.; Du, N. Biodegradation of crude oil by an Arctic psychrotrophic bacterium Pseudoalteromomas sp. P29. Curr. Microbiol. 2009, 59, 341–345. [Google Scholar] [CrossRef]
- Maiangwa, J.; Ali, M.S.; Salleh, A.B.; Rahman, R.N.; Shariff, F.M.; Leow, T.C. Adaptational properties and applications of cold-active lipases from psychrophilic bacteria. Extremophiles 2015, 19, 235–247. [Google Scholar] [CrossRef] [PubMed]
- Cavicchioli, R.; Siddiqui, K.S.; Andrews, D.; Sowers, K.R. Low-temperature extremophiles and their applications. Curr. Opin. Biotechnol. 2002, 13, 253–261. [Google Scholar] [CrossRef]
- Youenou, B.; Favre-Bonté, S.; Bodilis, J.; Brothier, E.; Dubost, A.; Muller, D.; Nazaret, S. Comparative Genomics of Environmental and Clinical Stenotrophomonas maltophilia Strains with Different Antibiotic Resistance Profiles. Genome Biol. Evolut. 2015, 7, 2484–2505. [Google Scholar] [CrossRef] [Green Version]
- Falagas, M.E.; Kastoris, A.C.; Vouloumanou, E.K.; Dimopoulos, G. Community-acquired Stenotrophomonas maltophilia infections: A systematic review. Eur. J. Clin. Microbiol. Infect. Dis. 2009, 28, 719–730. [Google Scholar] [CrossRef] [PubMed]
- Ryan, R.P.; Monchy, S.; Cardinale, M.; Taghavi, S.; Crossman, L.; Avison, M.B.; Berg, G.; van der Lelie, D.; Dow, J.M. The versatility and adaptation of bacteria from the genus Stenotrophomonas. Nat. Rev. Microbiol. 2009, 7, 514–525. [Google Scholar] [CrossRef] [PubMed]
- Pages, D.; Rose, J.; Conrod, S.; Cuine, S.; Carrier, P.; Heulin, T.; Achouak, W. Heavy metal tolerance in Stenotrophomonas maltophilia. PLoS ONE 2008, 3, e1539. [Google Scholar] [CrossRef] [Green Version]
- Antonioli, P.; Lampis, S.; Chesini, I.; Vallini, G.; Rinalducci, S.; Zolla, L.; Righetti, P.G. A new bacterial strain suitable for bioremediation of selenite-contaminated environmental matrices. Appl. Environ. Microbiol. 2007, 73, 6854–6863. [Google Scholar] [CrossRef] [Green Version]
- Vázquez, S.C.; Hernández, E.; Cormack, W.P.M. Extracellular proteases from the Antarctic marine Pseudoalteromonas sp. P96-47 strain. Rev. Argent. Microbiol. 2008, 40, 63–71. [Google Scholar]
- Zhou, M.Y.; Wang, G.L.; Li, D.; Zhao, D.L.; Qin, Q.L.; Chen, X.L.; Chen, B.; Zhou, B.C.; Zhang, X.Y.; Zhang, Y.Z. Diversity of both the cultivable protease-producing bacteria and bacterial extracellular proteases in the coastal sediments of King George Island, Antarctica. PLoS ONE 2013, 8, e79668. [Google Scholar] [CrossRef] [Green Version]
- Run, Y.; Zeng, R.; Zhang, J.; Zhao, N.W. Cold-active serine alkaline protease from the psychrophilic bacterium Pseudomonas strain DY-A: Enzyme purification and characterization. Extremophiles 2003, 7, 335–337. [Google Scholar]
- Kulakova, L. Cold-active serine alkaline protease from the psychrotrophic bacterium Shewanella strain ac10: Gene cloning and enzyme purification and characterization. Appl. Environ. Microbiol. 1999, 65, 611. [Google Scholar] [CrossRef] [PubMed] [Green Version]
- Morita, Y.; Hasan, Q.; Sakaguchi, T. Properties of a cold-active protease from psychrotrophic Flavobacterium balustinum P104. Appl. Microbiol. Biotechnol. 1998, 50, 669–675. [Google Scholar] [CrossRef] [PubMed]

| Feature | Value |
|---|---|
| Genome size/Mb | 5.77 |
| G + C content/% | 64.58% |
| Protein-coding genes (CDS) | 5536 |
| rRNA (5S, 16S, 23S) | 3 |
| tRNA | 55 |
| Other ncRNA | 54 |
Publisher’s Note: MDPI stays neutral with regard to jurisdictional claims in published maps and institutional affiliations. |
© 2022 by the authors. Licensee MDPI, Basel, Switzerland. This article is an open access article distributed under the terms and conditions of the Creative Commons Attribution (CC BY) license (https://creativecommons.org/licenses/by/4.0/).
Share and Cite
Peng, Y.; He, W.; Li, Y.; Liu, L.; Deng, B.; Yan, G.; Yang, J.; Wang, F.; Ma, L.; Wu, G.; et al. Degradation of CP4-EPSPS with a Psychrophilic Bacterium Stenotrophomonas maltophilia 780. Biomolecules 2022, 12, 318. https://doi.org/10.3390/biom12020318
Peng Y, He W, Li Y, Liu L, Deng B, Yan G, Yang J, Wang F, Ma L, Wu G, et al. Degradation of CP4-EPSPS with a Psychrophilic Bacterium Stenotrophomonas maltophilia 780. Biomolecules. 2022; 12(2):318. https://doi.org/10.3390/biom12020318
Chicago/Turabian StylePeng, Yanhong, Wencong He, Yunjing Li, Lu Liu, Binyang Deng, Guangbo Yan, Jun Yang, Fei Wang, Lixin Ma, Gang Wu, and et al. 2022. "Degradation of CP4-EPSPS with a Psychrophilic Bacterium Stenotrophomonas maltophilia 780" Biomolecules 12, no. 2: 318. https://doi.org/10.3390/biom12020318






